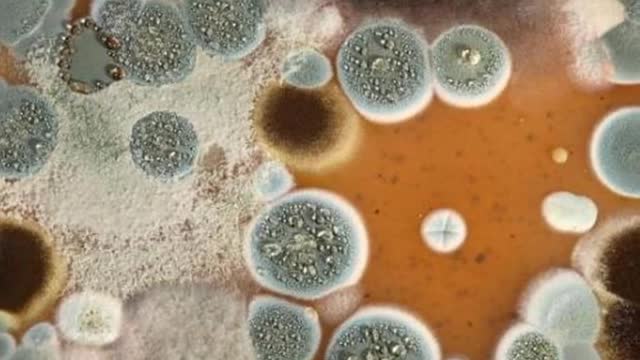

Premium Only Content
居家必備-茶樹精油 14種日常用途
茶樹精油有多種用途,包括保持皮膚、頭髮和指甲健康。
除了科學支持的好處外,茶樹精油在按照指示使用時價格便宜且安全。
本文討論了茶樹油的14種日常用途,並提供了安全有效地使用指導。
▲何謂茶樹精油,它是如何發揮作用?
茶樹精油來自互葉白千層的葉子,這是一種原產於澳大利亞昆士蘭州和新南威爾士州的小樹。
儘管互葉白千層被稱為茶樹,但不應將其與用於製作黑茶、綠茶和烏龍茶的植物茶葉混淆。
幾個世紀以來,茶樹精油一直被澳大利亞原住民用作傳統藥物。這些澳大利亞原住民將茶樹葉壓碎以提取油,然後將其吸入以治療咳嗽和感冒,或將其直接塗抹在皮膚上進行治療。
時至今天,茶樹油以100%未稀釋或純油的形式廣泛使用。還提供稀釋形式,在專為皮膚設計的產品中濃度為5-50%。
茶樹精油含有多種化合物,包括萜品烯-4-醇,已被證明可以殺死某些細菌、病毒和真菌。Terpinen-4-ol似乎還可以增加白細胞的活性,這有助於對抗細菌和其他外來入侵者。
這些抗菌特性使茶樹精油成為治療細菌和真菌皮膚病、預防感染和促進癒合的重要天然藥物。
▲茶樹精油的許多用途和好處:
1.洗手液
茶樹精油是理想的天然洗手液。
研究表明:它可以殺死導致疾病的幾種常見細菌和病毒,包括大腸桿菌、肺炎鏈球菌和流感嗜血桿菌。
事實上,一項測試洗手液的研究表明:在清潔劑中添加茶樹精油可以提高其對抗大腸桿菌的效果。研究證實:含有茶樹精油的洗手液對手部消毒有效,無需抗生素即可殺死細菌。
*結論:使用樹油作為天然洗手液有助於殺死許多導致感冒、流感和其他疾病的細菌。
2.驅蟲劑
茶樹精油有助於驅離討厭的昆蟲。
一項研究發現:用茶樹精油處理24小時後,奶牛的蒼蠅比未經處理的奶牛少61%。
茶樹精油用於使螞蟻遠離農業生產。它也是一種有效的驅蚊劑。一項試管研究表明:茶樹精油比避蚊胺(商業驅蟲劑中最常見的活性成分)具有更強的驅蚊能力。
*結論:茶樹精油已被證明可以殺死或驅除昆蟲。在某些情況下,它比標準殺蟲劑或驅蟲劑更有效。
3.天然除臭劑
茶樹精油的抗菌作用有助於控制與汗水有關的腋臭。
汗水本身沒有氣味。然而,當汗腺分泌物與皮膚上的細菌結合時,會產生中度至強烈的氣味。您的腋下含有大量這些腺體,通常所說的體味。茶樹精油的抗菌特性使其成為商業除臭劑和止汗劑的理想天然替代品。
*結論:茶樹精油含有對抗導致體臭的細菌的化合物。它可用於製作安全有效的除臭劑。
4.用於輕微割傷和擦傷的防腐劑
導致皮膚破損的傷害使細菌很容易進入您的血液,從而導致感染。茶樹精油可用於治療和消毒通過殺死金黃色葡萄球菌和其他可能導致開放性傷口感染的細菌產生輕微割傷和擦傷。
要對割傷或擦傷進行消毒,可執行以下步驟:
a.用普通肥皂和水徹底清潔傷口。
b.將一滴茶樹油與一茶匙椰子油混合。
c.將少量混合物塗抹在傷口上並用繃帶覆蓋。
d.每天重複這個過程一到兩次,直到結痂形成。
*結論:使用茶樹精油和椰子油的混合物有助於防止輕微割傷和擦傷被感染。
5.促進傷口癒合
除了防止割傷和擦傷感染外,茶樹精油還可以促進傷口癒合。
研究表明:茶樹精油有助於減少炎症並觸發有助於癒合過程的白細胞的活動。
茶樹精油是一種已知的抗菌、抗真菌和抗氧化劑,這些作用將有助於減少炎症和促進癒合。
在一項針對10名有傷口的人的小型研究中,在常規傷口治療中添加茶樹油會導致除癒合時間縮短。每次使用新敷料時,可以在傷口敷料中加入幾滴茶樹精油。
*結論:茶樹精油可以通過減少炎症和增加白細胞活性來幫助加速傷口癒合。
6.對抗粉刺
茶樹精油可以成為對抗粉刺的有力武器。多項研究表明,它有助於減少痤瘡的數量和總體嚴重程度。
一些痤瘡是由對傳統抗生素產生抗藥性的細菌引起的。對茶樹精油的科學檢查發現,應用不僅降低了細菌的活性,而且在實驗室4到6小時後殺死了它們。
在另一項研究中,發現茶樹精油對抗痤瘡的效果與最常見的抗痤瘡藥物過氧化苯甲酰一樣有效。
茶樹精油基痤瘡凝膠可以在天然雜貨店或在線零售商處購買。或者,您可以通過將一份茶樹油與九份水混合併,根據需要每天用棉籤將混合物塗抹在受影響的區域一次或兩次來進行痤瘡治療。
*結論:多項研究表明,含有茶樹精油的凝膠可減少痤瘡的病變數量和嚴重程度。
7.擺脫指甲真菌
真菌性指甲感染很常見。雖然它們並不危險,但它們可能很難看。有些藥物可以治療指甲真菌,但有些人可能更喜歡更自然的方法。茶樹精油已被證明在單獨使用或與其他自然療法結合使用時有助於擺脫指甲真菌,副作用比傳統藥物少。
在一項對照研究中,患有指甲真菌的人使用純茶樹油或抗真菌藥物6個月。在研究結束時,每組中約有60%的人經歷了真菌的部分或完全消退。
您可以單獨使用幾滴茶樹精油,也可以將其與等量的椰子油混合,然後塗抹在患處。塗抹後請務必立即洗手,以免將真菌傳播到其他區域。
*結論:茶樹精油似乎與應用於該區域的抗真菌藥物一樣有效對抗真菌指甲感染。
8.無化學成分的漱口水
研究表明,茶樹精油可以對抗導致蛀牙和口臭的細菌。
一項研究發現:茶樹精油比洗必泰(一種常見的消毒劑和漱口水)更能有效對抗導致牙菌斑的細菌。更重要的是,它的味道不那麼令人反感。
2020年的一項研究發現:茶樹精油漱口水是一種減少牙齦炎炎症的有效治療方法。
要製作自己的無化學成分漱口水,只需在一杯溫水中加入一滴茶樹油,充分混合,然後漱口30秒左右。像其他漱口水一樣,茶樹精油不應該被吞嚥。
*結論:茶樹精油可以用水稀釋製成漱口水,有助於對抗口臭和牙菌斑。
9.萬能清潔劑
茶樹精油是一種很好的多用途清潔劑,也可以消毒表面。此外,它不會留下您不希望您的家人或寵物接觸的化學物質的痕跡。
這是一個全天然、多用途清潔劑的簡單配方:
a.在噴霧瓶中混合20滴茶樹油、3/4杯水和1/2杯蘋果醋。
b.充分搖勻,直至徹底混合。
c.直接噴在表面上並用乾布擦拭乾淨。
d.確保每次使用前搖晃瓶子,以便將茶樹精油與其他成分混合。
*結論:茶樹精油可以與水和醋混合,為您的家創造一種不含化學物質的多用途清潔劑。
10.舒緩皮膚炎症
茶樹精油可能有助於緩解發炎的皮膚。
皮膚刺激的一種常見形式是接觸性皮炎,當您的皮膚與過敏原(例如鎳)接觸時就會發生這種情況。接觸過敏原會導致皮膚發紅、發癢,有時還會出現疼痛。
動物和人類研究都表明,使用茶樹精油可能有助於減輕這些症狀的嚴重程度。
在一項比較不同治療接觸性皮炎效果的研究中,發現茶樹精油可將症狀減輕40%,這顯著超過用於皮膚的標準藥物。
此外,茶樹精油可以通過減少身體釋放組胺以抵禦昆蟲唾液時發生的瘙癢、發紅和腫脹來緩解蚊蟲叮咬反應。
一項研究發現:將茶樹精油作為凝膠應用於紅斑痤瘡可減少炎症和發紅。
蠕形蟎性瞼緣炎是與蠕形蟎相關的眼睛和眼瞼周圍的炎症。茶樹精油已在全球範圍內用於治療這種刺激性病症,並已被發現可以減少蟎蟲的數量並減少炎症。
使用這個配方來緩解發炎的皮膚:
a.將10滴茶樹油與1湯匙特級初榨橄欖油和1湯匙融化的椰子油混合。
b.充分混合,並儲存在密封容器中。
c.適用於受影響的區域,每天最多兩次,直到症狀消失。
*結論:使用茶樹精油混合物可能有助於對抗與接觸性皮炎或昆蟲叮咬有關的皮膚炎症。
11.控制頭皮屑
頭皮屑或從頭皮上脫落的白色死皮片並不危險。但是,對於某些人來說,這可能會令人討厭和尷尬。
已發現在洗髮水中添加茶樹精油可以減少頭皮屑。這被認為與其抗真菌特性有關。而且因為它的酸性比你的皮膚略高,它有助於清除頭皮屑。
在一項研究中,發現茶樹精油洗髮水可有效減少通常會導致頭皮屑形成的白色念珠菌(酵母)的生長。
為了幫助減少頭皮屑,試著在洗頭時在一團洗髮水中加入幾滴茶樹油。
*結論:需要更多的研究,但已發現茶樹精油的抗真菌特性可以降低頭皮屑的嚴重程度並改善其他症狀。
12.治療腳氣
運動員的腳氣很難控制。
腳癬在醫學上被稱為足癬,是一種腳部傳染性真菌感染,也可以傳播到腳趾甲和手上。症狀包括脫皮、開裂、水泡和發紅。
抗真菌藥物被認為是腳癬的標準治療方法。然而研究表明,茶樹精油可能是緩解症狀的有效替代品。
在一項對158人進行的對照研究中,72%的茶樹精油組的腳癬有顯著的臨床改善,而安慰劑組為39%。
2020年的一項研究發現,茶樹精油可有效減少腳氣,但傳統療法和茶樹油的結合可能是解決此問題的更快方法。
這是緩解腳癬症狀的自然療法:
a.將1/4杯葛粉、1/4杯小蘇打和20-25滴茶樹精油混合。
b.攪拌混合併放入有蓋的容器中。
c.每天兩次塗抹在乾淨、乾燥的腳上。
*結論:茶樹精精油的抗真菌特性可能有助於緩解腳癬的症狀。
13.消除水果和蔬菜上的黴菌
新鮮農產品無疑是美味和健康的。不幸的是,它也容易受到稱為灰黴病菌的灰黴病的影響,特別是在溫暖潮濕的氣候中。
研究表明:茶樹精油的抗真菌化合物terpinen-4-ol和1,8-桉樹腦可能有助於減少這種黴菌在水果和蔬菜上的生長。
為了防止發霉,在沖洗農產品並徹底乾燥之前,在水中加入5-10滴茶樹精油。
*結論:茶樹精油含有化合物,有助於對抗水果和蔬菜上黴菌的生長。在沖洗農產品時將茶樹精油加入水中可能有助於您的農產品保持無霉菌。
14.緩解牛皮癬
牛皮癬是一種自身免疫性疾病,其特徵是皮膚出現紅色、發癢、鱗屑。
雖然藥物可以改善症狀,但病情本身是慢性的,沒有已知的治愈方法。
茶樹精油含有抗炎化合物,根據新出現的證據,這可能有助於緩解牛皮癬症狀。
為了緩解牛皮癬發作,將10-15滴茶樹油與2湯匙融化的椰子油混合。根據需要,每天將其塗抹在患處2-3次。
*結論:使用茶樹精油和椰子油的混合物可能有助於緩解牛皮癬的症狀。
▲使用茶樹精油的注意事項
研究表明,茶樹精油總體上是安全的。但是,在使用它之前需要注意一些事項。
不應吞入茶樹精油,因為如果吞食它可能有毒。將其存放在兒童接觸不到的地方。在一個案例中,一名18個月大的男孩在意外吞下茶樹精油後嚴重受傷。
在第一次使用茶樹油之前,先在一小塊皮膚上滴1或2滴,然後等待24小時,看看是否有任何過敏反應。這很重要,因為具有諷刺意味的是,一些使用茶樹精油的人會患上接觸性皮炎,這是茶樹精油可能有助於治療的疾病之一。
同樣,皮膚敏感的人在使用未稀釋的茶樹精油時可能會感到刺激。如果您的皮膚敏感,最好將茶樹精油與等量或更多量的橄欖油、椰子油或杏仁油混合。
此外,在寵物身上使用茶樹精油可能並不安全。研究人員報告說,在皮膚上或口服0.1-85毫升茶樹精油後,超過400隻狗和貓出現了震顫和其他神經系統問題。
*結論:雖然茶樹精油在成人皮膚上使用時通常是安全的,但某些人可能會出現過敏反應。茶樹精油可能對幼兒和寵物不安全。
▲總結
如您所見,茶樹精油之所以有幫助的原因有很多。它是基於化學的皮膚和指甲護理、個人護理產品和消毒劑等的廉價天然替代品。
然而,茶樹精油並不是萬靈藥。事實上,有些人在使用後可能會出現皮膚刺激或過敏反應。
總的來說,茶樹精油有多種用途,是手頭上的好東西。
特別推薦美樂佳公司的茶樹精油,該公司2006年全球業績高達8.5億美金,是全美500大企業之一,全球14個國家設有分公司,連續五年獲得美國藍籌獎,被華爾街日報經濟版評定為A+1的財務等級,顧客續購率高達95%。
如何識別茶樹精油之純度及優劣:T36-C5的指標:T代表純度,C代表刺激度,全世界純度最高,刺激度最低茶樹精油是T40-C3(頸部以上用),每瓶售價$25.50,T36-C5(頸部以下全身用)每瓶售價$18.50。
有關諮詢或購買茶樹精油,請洽「健康生活」商城:https://www.healthtodaynyc.com/shop。
更多其他話題內容:www.healthtodaynyc.com
-
2:43:41
Side Scrollers Podcast
16 hours agoAsmongold Says The Online Left Are “ANIMALS” + Hasan Collar-Gate Gets WORSE + More | Side Scrollers
7.15K9 -
1:33:41
Dinesh D'Souza
2 days agoThe Dragon's Prophecy Film
78.4K58 -
LIVE
Lofi Girl
2 years agoSynthwave Radio 🌌 - beats to chill/game to
517 watching -
44:08
The Why Files
6 days agoThe CIA, Men in Black and the Plot to Take Out JFK | The Maury Island Incident
36.7K61 -
2:07:23
TimcastIRL
7 hours agoTrump SLAMS China With NEW 100% Tariff, Stocks & Crypto TUMBLE | Timcast IRL
280K143 -
5:15:25
SpartakusLIVE
7 hours agoBF6 LAUNCH DAY || WZ and BF6 followed by PUBG - The PERFECT Combo?
52.7K2 -
1:33:59
Glenn Greenwald
9 hours agoQ&A with Glenn: Is the Gaza Peace Deal Real? Why was the Nobel Peace Prize Given to Venezuela's Opposition Leader? And More... | SYSTEM UPDATE #529
110K66 -
1:24:01
Flyover Conservatives
1 day agoURGENT FINANCIAL UPDATE! October 14–31: The Great and Terrible Day Has Arrived - Bo Polny; 5 Mindsets You Must Master - Clay Clark | FOC Show
46.2K4 -
4:01:36
VapinGamers
5 hours ago $3.04 earnedBattlefield 6 - All Protatoe and Nothing but Net - !rumbot !music
33.4K1 -
3:23:28
GritsGG
6 hours agoRANK GRIND! Most Wins in WORLD! 3734+!
26K